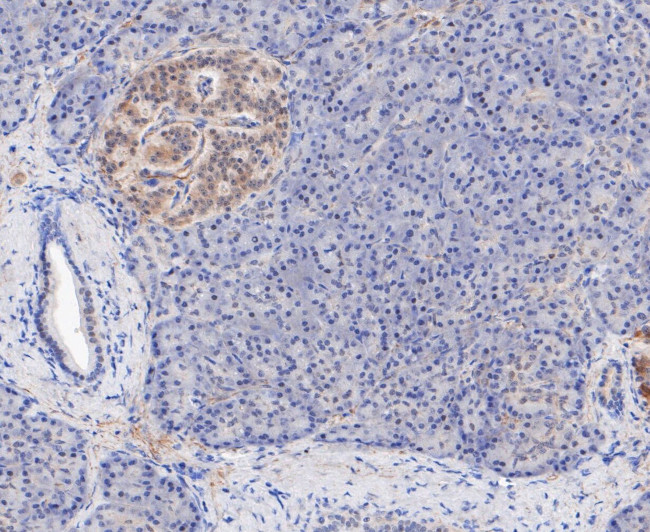
TPPP Antibody in Immunohistochemistry (Paraffin) (IHC (P))

Search
Invitrogen
TPPP Recombinant Rabbit Monoclonal Antibody (JE47-35)
{{$productOrderCtrl.translations['antibody.pdp.commerceCard.promotion.promotions']}}
{{$productOrderCtrl.translations['antibody.pdp.commerceCard.promotion.viewpromo']}}
{{$productOrderCtrl.translations['antibody.pdp.commerceCard.promotion.promocode']}}: {{promo.promoCode}} {{promo.promoTitle}} {{promo.promoDescription}}. {{$productOrderCtrl.translations['antibody.pdp.commerceCard.promotion.learnmore']}}
图: 1 / 4
TPPP Antibody (MA5-34851) in IHC (P)




Please note: We are reviewing Western blot images included in the antibody testing data in our catalog, including those provided by third parties. Unless expressly labeled or annotated as “raw-unedited”, Western blot images included in the antibody testing data in our catalog may have been edited, optimized or otherwise adjusted for presentation.
产品信息
MA5-34851
种属反应
宿主/亚型
Expression System
分类
类型
克隆号
抗原
偶联物
形式
浓度
规格
纯化类型
保存液
内含物
保存条件
运输条件
RRID
产品详细信息
Positive Control: Mouse brain tissue, rat brain tissue, human pancreas tissue, human uterus tissue, SHG-44.
靶标信息
Tubulin family members are globular proteins important in the assembly of microtubules. Microtubules are structural components that play important roles in mitosis, cytokinesis and vesicle transport. TPPP (Tubulin polymerization-promoting protein), also known as p24 and p25, is a widely expressed 219 amino acid protein found in the perinuclear region of the cytoplasm. TPPP may form dimers and functions in polymerizing tubulin into double-walled tubules, polymorphic aggregates, or stabilized blocks. TPPP overexpression prevents formation of the mitotic spindle assembly and breakdown of the nuclear envelope. TPPP is phosphorylated by TPK II and is encoded by a gene that maps to human chromosome 5, which contains 181 million base pairs and comprises nearly 6% of the human genome. May play a role in the polymerization of tubulin into microtubules, microtubule bundling and the stabilization of existing microtubules, thus maintaining the integrity of the microtubule network. May play a role in mitotic spindle assembly and nuclear envelope breakdown.
仅用于科研。不用于诊断过程。未经明确授权不得转售。
篇参考文献 (0)
生物信息学
蛋白别名: 25 kDa brain-specific protein; p24; p25-alpha; TPPP; TPPP/p25; Tubulin polymerization-promoting protein
基因别名: TPPP; TPPP1
Entrez Gene ID: (Human) 11076